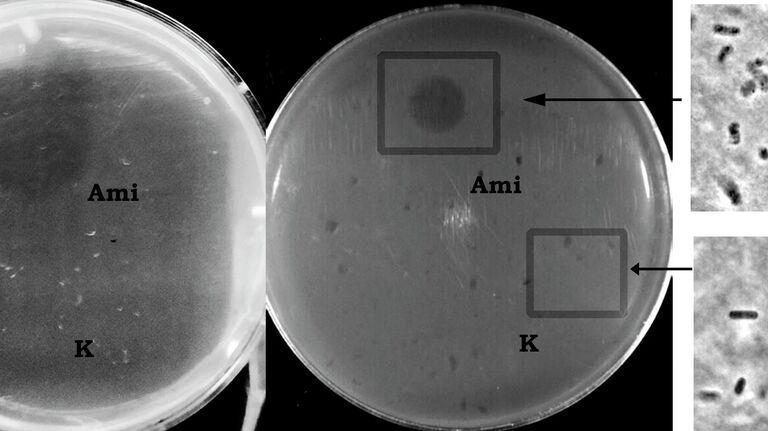
Чашки Петри с вплавленными в агар живыми клетками Bacillus

МОСКВА, 28 июл — РИА Новости. Неизвестный ранее фермент, способный стать основой для новых противомикробных препаратов, выделили из микроорганизма Lysobacter capsici ученые Института биохимии и физиологии микроорганизмов имени Г.К. Скрябина РАН. Он разрушает стенки бактерий с большей эффективностью, чем другие белки со схожим действием, рассказали РИА Новости в Российском научном фонде.
Разрушение клеточных стенок приводит к гибели микроорганизма, причем к такому воздействию он не может выработать устойчивость, как к некоторым антибиотикам, подчеркнули в пресс-службе Российского научного фонда (РНФ).
Ученые Института биохимии и физиологии микроорганизмов имени Г.К. Скрябина РАН (ИБФМ РАН) обнаружили, что бактерии Lysobacter capsici вырабатывают неизвестный ранее науке фермент, способный разрушительно воздействовать на стенки бактериальных клеток.
"В настоящее время мы выделили и описали 12 внеклеточных ферментов Lysobacter capsici, среди них есть ферменты, противодействующие стрептококкам, стафилококкам и энтерококкам, включая устойчивые к антибиотикам штаммы патогенных бактерий (супербактерии), а новый, тринадцатый, особенно эффективен против бацилл", — рассказала старший научный сотрудник лаборатории биохимии клеточной поверхности Ирина Кудрякова.
Чашки Петри с вплавленными в агар живыми клетками Bacillus
© Фото : Ирина Кудрякова
1 из 2

Продуцент перспективных внеклеточных бактериолитических ферментов — Lysobacter capsici XL1
© Фото : Ирина Кудрякова
2 из 2
Чашки Петри с вплавленными в агар живыми клетками Bacillus
© Фото : Ирина Кудрякова
1 из 2
Продуцент перспективных внеклеточных бактериолитических ферментов — Lysobacter capsici XL1
© Фото : Ирина Кудрякова
2 из 2
Препарат с новым ферментом — амидазой Ami — может разрушать клетки возбудителей пищевых отравлений и использоваться для борьбы с сибирской язвой, сообщили в РНФ. "Ответственный" за производство этого белка ген также обнаружен учеными, что позволяет "встроить" его в собственные клетки Lysobacter capsici и увеличить количество производимого микроорганизмом белка.
"На следующем этапе ученые получили фермент Ami в достаточном количестве для его всестороннего изучения. Для этого с использованием оригинальных молекулярно-генетических подходов авторы "заставили" клетки Lysobacter capsici нарабатывать необходимое количество амидазы Ami. Фермент продемонстрировал высокую антимикробную активность в отношении ряда патогенных бактерий, включая устойчивые к антибиотикам штаммы", — добавили в РНФ.
В будущем специалисты ИБФМ РАН планируют установить пространственную структуру амидазы Ami и использовать эти данные для модификации этого фермента, что сделает возможным "программирование" свойств лекарств, в том числе на его основе. Результаты исследования представлены в Scientific reports.
Работа выполнена при поддержке Российского научного фонда.